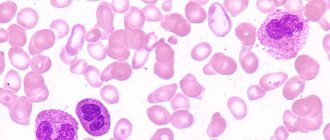

Самым тяжёлым заболеванием поджелудочной железы является геморрагический панкреонекроз. Это процесс необратимого умирания её клеток, который происходит с большой скоростью. Болезнь бывает продолжением острого панкреатита. Такой панкреатит возникает в результате интоксикаций, механических повреждений, осложнений после хирургического вмешательства. Панкреонекроз появляется также от обострения хронических болезней поджелудочной железы.
У здорового человека железой вырабатывается панкреатический сок, который перерабатывает белки для пищеварительной системы. Ферменты в составе сока удаляются из поджелудочной железы в двенадцатиперстную кишку. В случае нарушения выработки секретами этих ферментов возникает их неконтролируемое скопление, что и приводит к саморазрушению поджелудочной железы. Повреждаются ткани и кровеносные сосуды. Появляются кровоизлияния. Вскоре умершие клетки занимают всё больше участки (некроз). Скорость процессов зависит от степени производства лишних ферментов.
Такая патология затрагивает нормальное функционирование всего организма. Расстраивается пищеварительная система, резко снижается иммунитет. Медицинская статистика показывает неутешительные данные. Геморрагический панкреонекроз является причиной смерти в 7 – 15 процентах при его диагностировании.
Причины заболевания
Медицинская теория возникновения этой опасной болезни не пришла к единому мнению по поводу причин, её вызывающих. Но врачебная практика позволяет утверждать, что провоцируют появление геморрагического панкреонекроза следующие факторы:
- если ранее возникали воспаления поджелудочной железы, которые привели к частичной потере её функций,
- если нарушается вывод панкреатического сока,
- если имели место глобальные отравления в результате алкоголя или химических веществ,
- если случались инфекционные болезни желчевыводящих протоков: холангит, холецистит и др.,
- если повышается свёртываемость крови в результате прошедших вирусных заболеваний, лечебного воздействия с использованием химических средств,
- если в организме присутствуют аутоиммунные патологии геморрагического вида,
- если травмируется паренхима железы из-за механических действий, например, хирургических проникновений,
- если проводилось лечение онкологии химиотерапией или излучением, и на этом фоне возник ДВС-синдром.
Эти причины нарушают функционирование ацинуса, который и отвечает за производство ферментов. Гастроэнтерологи выявили из результатов проведённых исследований, что одну из важных ролей в появлении панкреонекроза играет нарушение гуморальной регуляции. Эта функция управляет жизнедеятельностью человека посредством крови, лимфы, других жидких сред с помощью гормонов
Прогноз жизни
Панкреонекроз геморрагического характера имеет крайне неблагоприятный прогноз. Даже при своевременном начале лечения в половине случаев наблюдается гибель пациента. При отказе от терапии этот показатель приближается к 100%.
Причины смерти
Главные причины внезапной, скоропостижной смерти при панкреонекрозе:
- септические осложнения, нарушающие функции всех органов;
- инфекционно-токсический шок, из-за которого инфекцию считают негативным фактором в течении патологии;
- необратимое изменение структуры поджелудочной железы;
- тотальный некроз тканей;
- реактивные изменения в пораженных тканях.
В вышеописанных ситуациях смерть наступает мгновенно либо через несколько суток. Крайне редко пациент проживает больше 2 недель.
Симптоматика патологии
Опасность патологии заключается в том, что при данном заболевании существуют довольно специфические признаки, по которым с высокой вероятностью его можно диагностировать. Проблема в том, что геморрагический панкреонекроз развивается очень быстро, и пациенты попадают в больницу поздно. И в этой ситуации даже современные методы лечения не могут помочь. У одного заболевшего из пяти случается коллапс, треть из них впадает в состояние комы. Особенно часто разрываются ткани поджелудочной железы. Панкреатический сок оказывается в брюшной полости, становится причиной гнойного перитонита. Чтобы избежать худшего, надо знать симптомы, которые присущи панкреонекрозу:
- сильная боль в левом подреберье, которая может отдавать как в грудь с плечами, так и в поясницу,
- появление явного налёта на языке, который окрашен в белый или жёлтый цвет,
- нестерпимая сухость во рту, избавиться от которой невозможно,
- беспрерывная рвота, тошнота,
- метеоризм,
- диарея,
- лихорадочное состояние из-за сильного отравления,
- повышение температуры,
- воспаление кожи в районе лица,
- посинение живота,
- нарушение кровяного давления,
- резкое снижение работы выделительной системы (мочи, кала),
- пороговые уровни психоэмоционального состояния (депрессия, агрессивность).
Боль в левом подреберье
Смертность и прогноз
Смертность от геморрагического панкреонекроза составляет 7-15%, при тяжелом течении – 40-70%. Заболевание приводит не только к нарушению функционирования поджелудочной железы, но и всего организма. У больного снижается иммунитет, нарушается процесс пищеварения.
Геморрагический панкреонекроз может стать причиной некроза клеток других органов, которые располагаются вблизи поджелудочной железы.
Наиболее распространенная причина смерти от этой болезни – интоксикация организма вследствие гнойного перитонита.
Прогноз на выздоровление благоприятный только при раннем обращении в больницу и корректной терапии. После лечения нужно соблюдать диету и отказаться от вредных привычек.
Диагностика заболевания
Поставить точный диагноз могут только врачи после комплексного обследования: компьютерной диагностики, лабораторных анализов. При подозрении на геморрагический панкреонекроз назначаются:
- УЗИ поджелудочной железы,
- КТ всего состояния органов брюшной полости,
- МРТ,
- стандартные анализы крови, мочи,
- определение состава панкреатического и желудочного соков.
Кровь оценивают на содержание ферментов, вырабатываемых железой. В моче обращают внимание на концентрацию трипсиногена, амилазы. Важны также кислотность желудочного сока, количество ферментов в панкреатическом соке, жиры в кале, триглицериды в лёгких. Может понадобиться взятие пункции мёртвых тканей.
Совокупность полученных результатов поможет отличить это заболевание от иных острых патологий желудка и кишечника. В отдельных случаях пациенты попадают в медицинское учреждение в таком состоянии, что сразу приходится проводить лапароскопию без предварительных исследований.
Проявления панкреонекроза
Развитие заболевания происходит поэтапно:
- Первый — в поджелудочной железе активно развиваются бактерии, вызывая токсинемию и усиление аутоагрессии панкреатических ферментов. Начинается лихорадка, рвота, неустойчивый стул.
- Второй — начинается гнойный и ферментативный распад клеток железы, с формированием провалов в органе.
- Третий — воспаление переходит на соседние ткани, вызывая стресс-реакцию организма.
Проявляется острой опоясывающей болью, отдающей в левую часть тела. Без болей данное заболевание не бывает. Сопровождается безудержной рвотой, которая не приносит облегчения, с выделением желчи, частиц крови. Развивается обезвоживание, пересыхает кожа и слизистая, обложен язык, снижается объем мочи. Повышается газообразование и стул становится нерегулярным.
При осмотре пациента наблюдается вздутие живота, а также появляются пятна синего или фиолетового цвета по бокам, вокруг пупка, на ягодицах. Это признак кровотечений в кишечно-желудочном тракте, так как эластаза (фермент) разрушает кровеносные сосуды.
Лечение болезни
При возникновении у человека острой стадии геморрагического панкреонекроза госпитализация является обязательной. Тем более опасно использование самостоятельного лечения. Причина смерти окажется в несвоевременном врачебном вмешательстве. При таком диагнозе есть два варианта: больной попадает в реанимационное отделение или на операционный стол. Общая терапия выполняет следующие задачи:
- купируются острые болевые ощущения,
- останавливается излишняя выработка панкреатических ферментов,
- снимаются спазмы,
- уменьшается выделение желудочного сока,
- предотвращается проникновение инфекции.
Реанимационные меры должны применяться без промедления. Применяются спазмолитики. Быстрое действие оказывает «Новокаин». Протоки расширяются, и панкреатический сок выводится беспрепятственно. С первых часов используются противоферментные и антибактериальные препараты, снижается секреторная функция и предотвращается омертвение тканей.
После нескольких часов такой терапии врачи смотрят на её результативность, взвешивают все «за» и «против». Принимают решение о необходимости оперативного вмешательства. Если форма болезни не носит инфекционного характера, то показано применение лапароскопии. Возможно использование дренажа полости через кожу. Если обнаруживается обильный экссудат, то надо выполнять операцию на полости. Положительный эффект последует от процедуры перитонеального диализа. Благодаря ему из крови удаляются ферменты и токсичные вещества, резко уменьшается риск смертельного исхода.
При распространённом панкреонекрозе может понадобиться частичное удаление поджелудочной железы (редко полное). Сразу после хирургического вмешательства назначается обычное лечение. В этом случае обязательными становятся лекарства, которые специализируются на поддержании работы железы.
Терапия
Первое, в чем нуждается пациент – это адекватное обезболивание и борьба с шоком. Для этого больному вводят растворы электролитов и белковые препараты крови (Полиглюкин, Реополиглюкин, Гемодез, плазма и альбумин). Для обезболивания используют наркотические анальгетики (Промедол, Диазепам). В некоторых случаях их дополняют антигистаминными препаратами 1-го поколения, которые оказывают не только противоаллергический, но и седативный эффект.
Обязательным пунктом терапии является снятие спазма сфинктера. Для этого применяются препараты спазмолитики (Платифиллин, Папаверин, Эуфиллин). Сильная рвота может спровоцировать дисбаланс электролитов. Поэтому больному в реанимации часто вводят растворы калия, кальция, магния. Они способствуют нормализации работы сердечной мышцы.
Для уменьшения повреждающего действия ферментов вводят препараты, снижающие действие протеаз (Трасилол, Контрикал). Также активность железы тормозят гормональные препараты (Октреоцид, Сандостатин). Они уменьшают зону некроза. При профилактическом их введении во время манипуляций на железе снижается агрессия ферментов.
При панкреонекрозе процесс распространяется за пределы органа, формируя очаги поражения в окружающих тканях. Поэтому оперативное лечение при таком виде панкреатита – это жизненная необходимость. Обширные полостные операции имеют плохой прогноз. Врачи отдают предпочтение лапароскопическим вмешательствам. При этом удаляются очаги некроза, в инфильтраты вставляются дренирующие трубки.
В том случае, когда все методы не дают должного эффекта, наступает летальный исход. При этой форме болезни он может наступить в первые сутки заболевания. При адекватном лечении, но слабых защитных силах организма больные умирают через 1-2 недели после приступа. Основными причинами летальности становятся гнойно-септические осложнения, пневмонии, полиорганная недостаточность, инфекционно-токсический шок. У выживших пациентов панкреонекроз приводит к инвалидности.
Профилактика патологии
Для восстановления после оперативного вмешательства нужно не менее четырёх месяцев. При этом показаны: специальное питание, покой с минимумом нагрузок и реабилитационная терапия. Назначается курс приёма таблеток с инсулином, ферментных лекарств, физиотерапии.
Лечебную диету с ограничениями нужно соблюдать в течение всей жизни. Пищу принимают по 5 – 6 раз в день маленькими порциями. Время приёма одно и то же. Показано овощи варить или готовить на пару. Каши только на воде, нежирные кисломолочные продукты. Из мяса рекомендуется птица. Запрещается кушать свежие фрукты и овощи, продукты фастфуда, спиртные напитки, молоко, консервацию.
Чтобы предотвратить возникновения геморрагического панкреонекроза, необходимо соблюдать простые правила здорового образа жизни. Употребляйте больше свежих овощей и фруктов, цельные крупы, орехи, растительные масла, морепродукты. Откажитесь от жирных продуктов, полуфабрикатов, большого количества сахара и соли. Пейте больше чистой воды. Бросьте курить, не злоупотребляйте алкоголем, двигайтесь и почаще бывайте на свежем воздухе. Избегайте стрессовых ситуаций и проходите регулярное медицинское обследование.